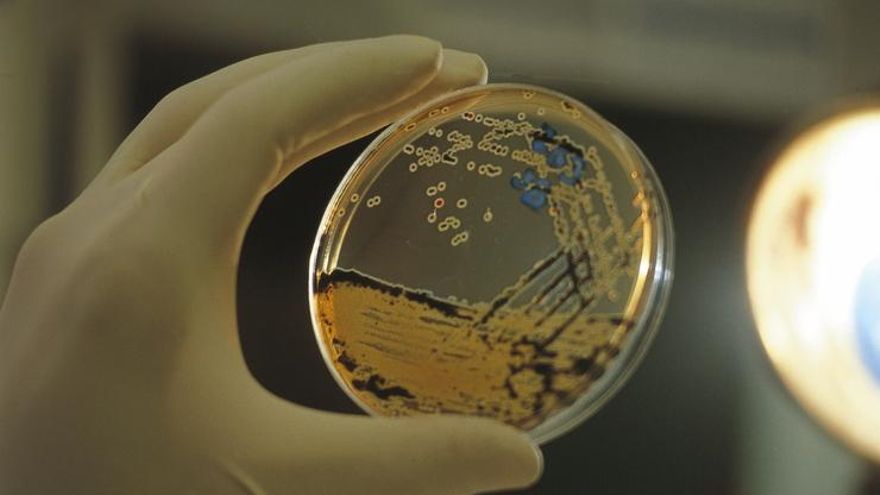

Euskadi renueva su compromiso con la ciencia y la tecnología

El Consejo Vasco de Ciencia y Tecnología ha acordado una inversión de 446 millones de euros por parte de todas las instituciones vascas para el próximo año, un 5% más que en 2015. Serán 20 millones más para impulsar la estrategia de I+D+i.
En la décimo quinta edición de la Semana de la Ciencia, la Tecnología y la Innovación celebrada en Bilbao en noviembre, el lehendakari Íñigo Urkullu ya reiteró que el impulso de la investigación científica y la innovación tecnológica es un “reto prioritario” para Euskadi, por lo que el Ejecutivo va a invertir 11.100 millones de euros hasta el año 2020 para desarrollar hasta ese año 40 líneas estratégicas de investigación. “La clave es mantener el espíritu de colaboración para seguir invirtiendo en el nuevo futuro económico de Euskadi”.
En la reunión celebrada en Lehendakaritza hace dos semanas, presidida por Urkullu y a la que han asistido representantes del Gobierno Vasco, las diputaciones forales, las tres universidades vascas y entidades públicas y privadas ligadas a la innovación, se ha cerrado el acuerdo para impulsar la estrategia de I+D+i. Las instituciones vascas invertirán el próximo año 446 millones de euros. El grueso de esta cantidad, 385 millones, los aporta el Gobierno Vasco y las Diputaciones Forales destinarán 61 millones de euros en actividades de innovación e investigación.
A la cantidad dispuesta por las administraciones vascas hay que sumarle 80 millones de euros en programas correspondientes a la administración general del estado. En total, la inversión en I+D+I en Euskadi para 2016 será de 526 millones de euros, superando en 20 millones de euros la propia previsión establecida en el Plan de Ciencia y Tecnología Vasco para ese mismo periodo. Se trata de una cifra que, a juicio de los integrantes del Consejo, muestra “una clara apuesta por hacer de la investigación el motor del desarrollo y de la competitividad de la industria vasca”.
El lehendakari ha encabezado el encuentro del Consejo en el que también se ha realizado un balance de las actuaciones desarrolladas en el primer año de ejecución de la estrategia Vasca de Desarrollo inteligente “RIS3 Euskadi” y se ha analizado el avance global del Plan de Ciencia y Tecnología e Innovación (PCTI) aprobado en diciembre del pasado año. En este primer año de ejecución se han cumplido todos los objetivos previstos para implantar las tres prioridades estratégicas de Euskadi en el horizonte del 2020: la fabricación avanzada, la energía, y las biociencias-salud.
Además de estas tres prioridades, se han impulsado también los denominados “cuatro territorios de oportunidad” como son alimentación, ecosistemas medioambientales, hábitat urbano, industrias culturales y creativas.

Para poder desarrollar estas materias en 2015 se han puesto en marcha 7 grupos de pilotaje compuestos por representantes de los tres ámbitos de la denominada “hélice de la innovación”: administraciones vascas; empresas y clúster, y agentes científico-tecnológicos. Estos siete grupos de pilotaje han comenzado ya a desarrollar su trabajo en tres ámbitos: la selección de las áreas y tecnologías estratégicas para Euskadi en el próximo futuro; la identificación de los proyectos más relevantes actualmente en marcha y la puesta en marcha de grupos de trabajo específicos en su seno para desarrollar la estrategia de impulso y colaboración entre todos los agentes vascos en cada una de las áreas establecidas.
El objetivo último es aumentar la excelencia de los proyectos de investigación desarrollados y lograr que Euskadi sea una referencia europea en las prioridades RIS3 ya fijadas.
Además, y con un carácter divulgativo, se ha procedido a identificar a las personas más relevantes del sistema científico vasco atendiendo a su excelencia, prestigio internacional y reconocimientos europeos en sus campos de disciplina.
Sobre este blog
Espacio destinado a la difusión de las iniciativas y programas que está llevando a cabo el Gobierno vasco para la reactivación económica en Euskadi. Los contenidos detallan temas como la industria vasca, la innovación, la internacionalización o la revolución de la industria 4.0.
Industria vasca 4.0 es un blog patrocinado por el Departamento de Desarrollo Económico y Competitividad del Gobierno vasco





